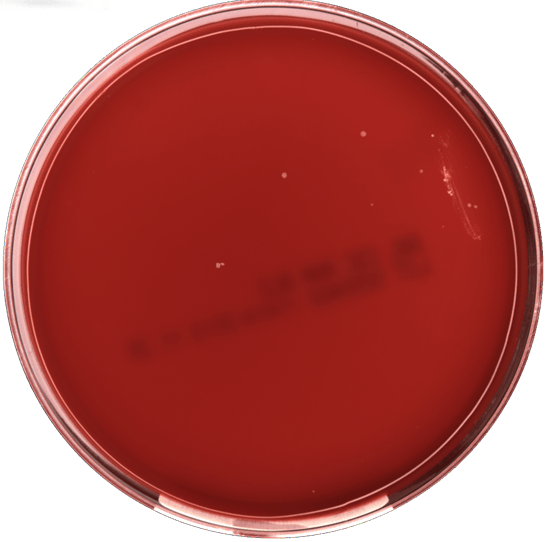

Case History
A 18 year old male with no significant past medical history presented with 2-3 month cough, hemoptysis, fevers, night sweats and 15 pound unintentional weight loss. He originally started to feel mild shortness of breath with activity following his return from the Pacific Northwest. He was diagnosed with pneumonia and given antibiotics. He denied vaping, hookah use or any smoking. Of note, his maternal grandmother had pulmonary tuberculosis two years ago, but at that time he had a negative interferon-gamma release assay (IGRA). Since that time he had traveled extensively including Europe and Asia.
Upon admission, physical examination showed decreased breath sounds and coarse crackles in the right lower lung field. His blood test results were unremarkable. Chest X-ray and CT scan showed diffuse reticular pattern and a 4 cm cavitary lesion in his right lower lobe (Image 1). Brochoalveolar lavage fluid, sputum as well as blood were submitted to microbiology lab for bacterial, fungal and mycobacterial culture.

Laboratory results and management
The patient’s Quanti FERON®-TB Gold test (an IGRA) was positive.Laboratory studies including fungal culture to look for endemic fungi and HIV were negative. Auramine-rhodamine (acid fast) staining of sputum smear showed 4+ acid fast bacilli (AFB). Mycobacterium tuberculosis was confirmed by both our laboratory developed TB-PCR assay and a commercial TB-PCR assay (Xpert MTB/RIF). DNA sequencing was performed by the Centers for Disease Control and Prevention (CDC) in order to predict antibiotic susceptibility profiles for first-line anti-tuberculosis drugs including Ethambutol, Isoniazid, Pyrazinamide, and Rifampin. Because the result showed drug-susceptible tuberculosis, the patient started the first-line anti-tuberculosis drugs. Four days after admission, the patient discharged home with follow up with the department of health. After six weeks incubation, the sputum culture grew Mycobacterium tuberculosis with a pan-susceptible antibiotic profile.

Discussion
Mycobacterium tuberculosis (MTB) remains a global health problem. The continuing spread of drug-resistant tuberculosis is one of the most difficult challenges for MTB control. The CDC recommends rapid laboratory confirmation of MTB with using a nucleic acid amplification test (NAAT), followed early drug susceptibility testing. Our case is consistent with the previous reports that NAAT can identify MTB and DNA sequencing can determine the drug susceptibility within a few days. Our case can be summarized into two points.
First, early NAAT provided diagnosis MTB within 2 days after patient admission, enabling the timely initialization of infection control measures. Although culture remains the gold standard for laboratory confirmation of active TB infection, it can take 6-8 weeks to grow in a culture media since MTB is slow growing pathogen. Early laboratory confirmation of MTB with NAAT led rapid initiation of the patient treatment and transmission interruption.
Second, DNA sequencing guided us to start an optimal anti-tuberculosis treatment within 3 days because of the accurate prediction of susceptibility profiles for first-line anti-tuberculosis drugs. In comparison, the conventional susceptibility testing with the drug-containing medium requires 1 month to complete beyond initial growth and identification of the organism. Recent studies demonstrated high accuracy of genotypic predictions (>91.3 % sensitivity; >93.6% specificity). Our case supports a theory that DNA sequencing can help to determine which anti-tuberculosis drugs should be used for treatment.
Despite the notable advantage, NAAT has limitations. There is a relatively low positive predictive value in smear-negative pulmonary MTB. Recent meta-analysis found that overall sensitivity of NAAT to be 90.4% for diagnosis of pulmonary MTB. The sensitivity of the NAAT further defined to be lower in smear negative (75%) compared to smear positive (98%) pulmonary MTB. Additionally, cost effectiveness of NAAT and DNA sequencing is another concern. Further assessments of the benefit of NAAT and DNA sequencing utilization for smear negative MTB are needed.
In conclusion, our case demonstrated that NAAT and DNA sequencing was beneficial to reduce the time to initiation of an optimal MTB management.
References
- Prediction of Susceptibility to First-Line Tuberculosis Drugs by DNA Sequencing. N Engl J Med 2018; 379: 1403-15.
- Use of Nucleic Acid Amplification Tests in Tuberculosis Patients in California, 2010-2013. Open Forum Infect Dis. 2016 Oct; 3(4): ofw230.
- Assessment by Meta-Analysis of PCR for Diagnosis of Smear-Negative Pulmonary Tuberculosis. J Clin Microbiol. 2003 Jul; 41(7): 3233-3240.

-Sachie Ikegami MD, PhD is a 1st year anatomic and clinical pathology resident at University of Chicago (NorthShore). Sachie’s academic interests include neuropathology and molecular pathology. She is passionate about understanding how pathology informatics improving clinical practice. Outside of the lab, she enjoys jogging.

-Erin McElvania, PhD, D(ABMM), is the Director of Clinical Microbiology NorthShore University Health System in Evanston, Illinois. Follow Dr. McElvania on twitter @E-McElvania.